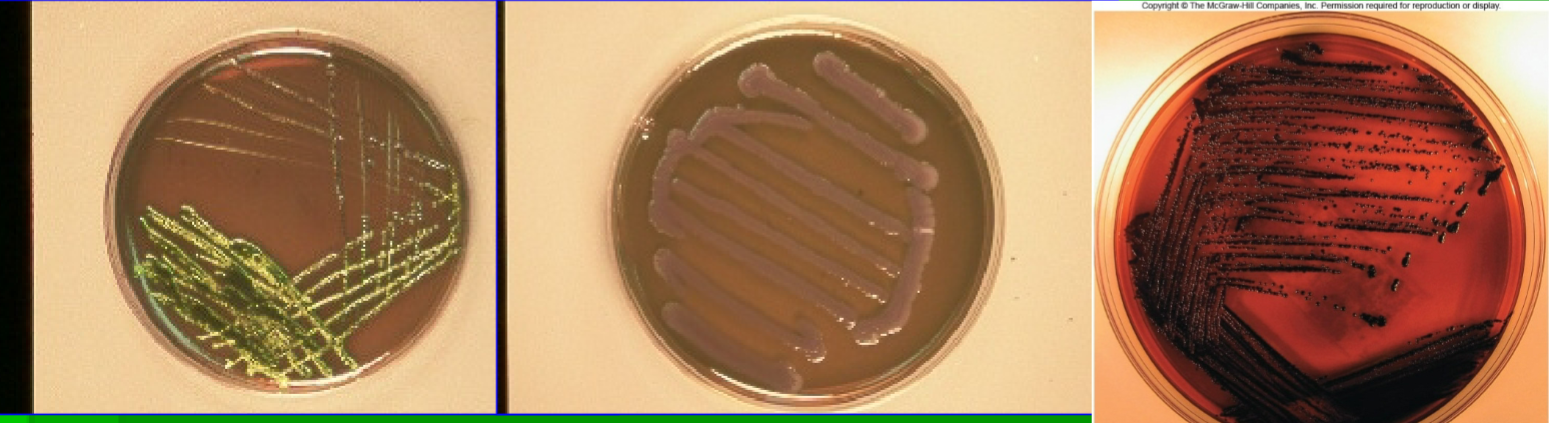
<p>Eosin Methylene Blue (EMB) type</p>
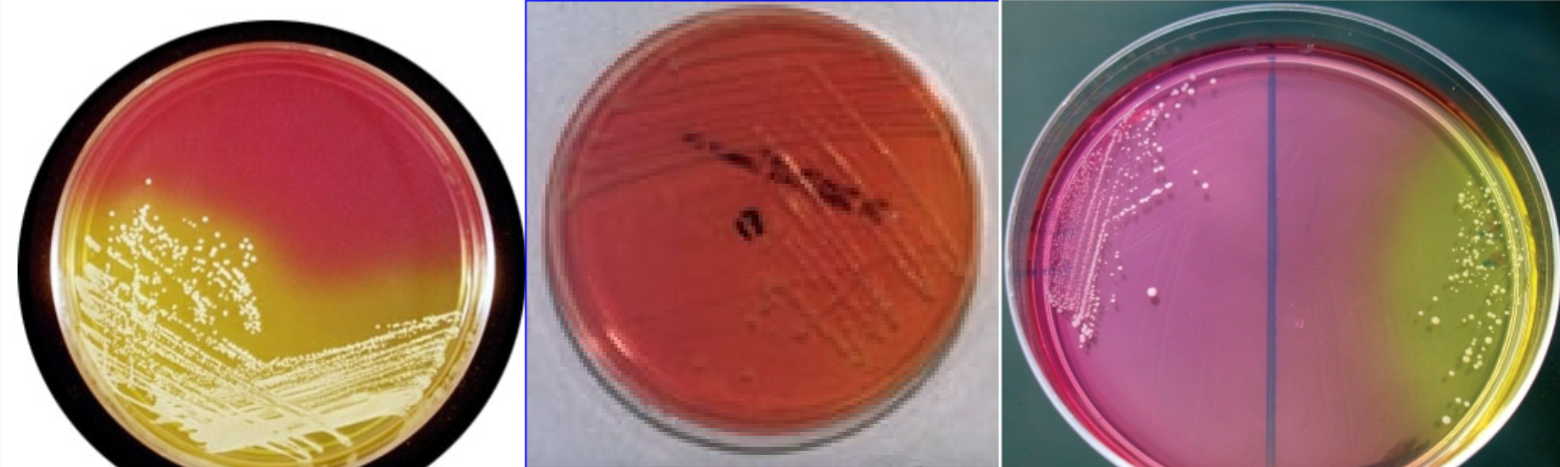
<p>Mannitol Salt Agar (MSA) product</p>
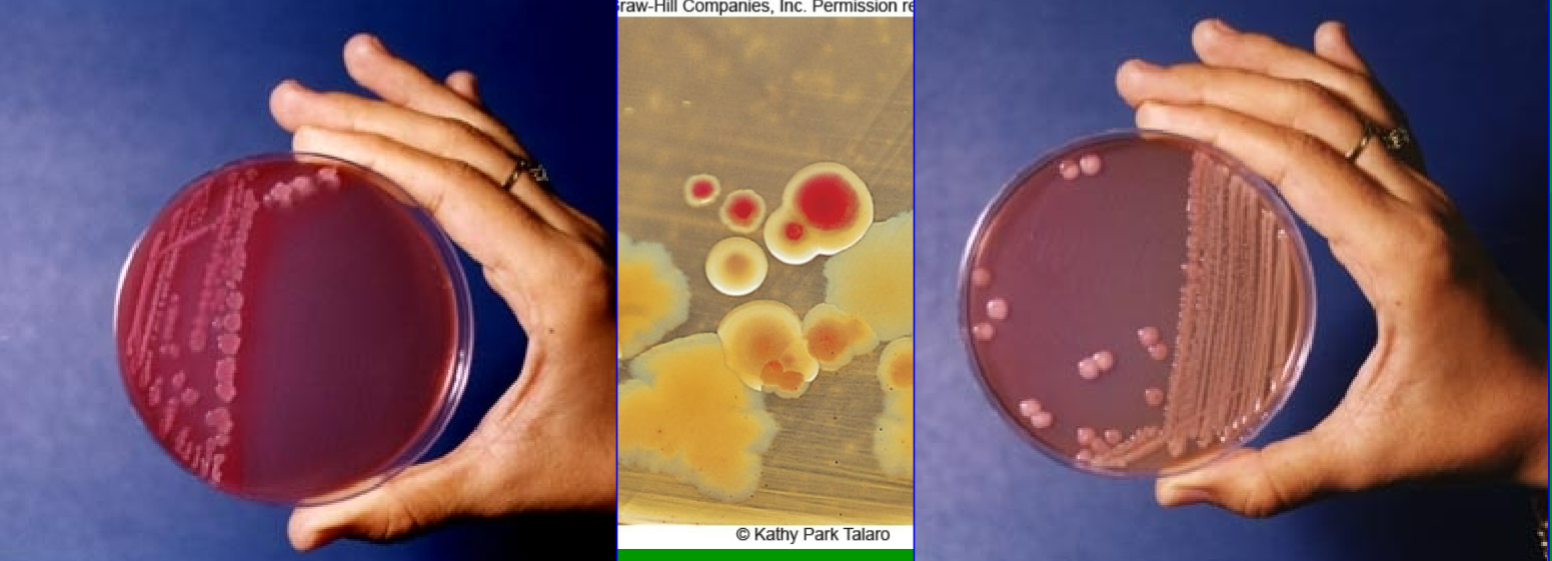
<p>MacConkey Agar substrate</p>
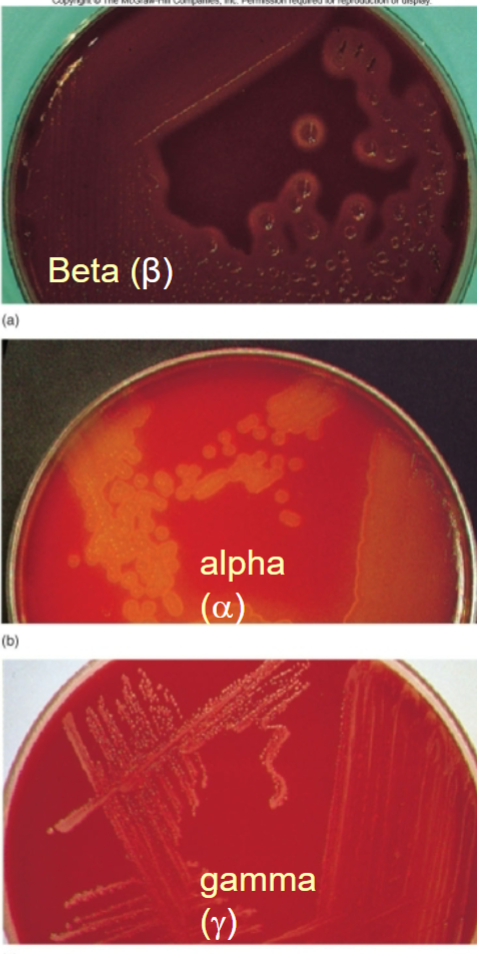
<p>What does hemolysis look like in gamma cells?</p>
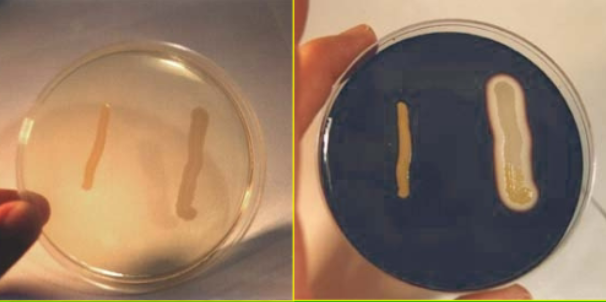
<p>Starch Agar product?</p>

Microbial Identification Tests: Urea Broth, Gelatin Hydrolysis, EMB, MSA, and MacConkey Agar
1/91
There's no tags or description
Looks like no tags are added yet.
Name | Mastery | Learn | Test | Matching | Spaced | Call with Kai |
|---|
No analytics yet
Send a link to your students to track their progress
92 Terms

Urea Broth tests for
Urease

Urea Broth substrate
Urea

Urea Broth product
Ammonia

Urea Broth positive result
Pink

Urea Broth type
Differential

Nutrient Gelatin tests for
Gelatin Hydrolysis

Nutrient Gelatin substrate
Gelatin

Nutrient Gelatin product
Amino acids

Nutrient Gelatin positive result
Turns liquid

Nutrient Gelatin type
Selective

Eosin Methylene Blue (EMB) tests for
Coliforms (Gram-negative rods)

Eosin Methylene Blue (EMB) substrate
Lactose

Eosin Methylene Blue (EMB) product
Acid

Eosin Methylene Blue (EMB) positive result
Purple, green, or black colonies
Eosin Methylene Blue (EMB) type
Selective & Differential

Mannitol Salt Agar (MSA) tests for
Staphylococcus (Halophiles)

Mannitol Salt Agar (MSA) substrate
Salt / Mannitol
Mannitol Salt Agar (MSA) product
Acid

Mannitol Salt Agar (MSA) positive result
Yellow

Mannitol Salt Agar (MSA) type
Selective & Differential

MacConkey Agar tests for
Coliforms
MacConkey Agar substrate
Lactose

MacConkey Agar product
Acid

MacConkey Agar positive result
Red colonies

MacConkey Agar type
Selective & Differential

Phenol Red Broth tests for?
Carbohydrate fermentation
Production of an acid or a gas through fermentation

Phenol Red Broth substrate?
Sugars (Glucose, Lactose, Sucrose)

Phenol Red Broth Product?
Pyruvic acid

Phenol Red Broth Positive result?
Yellow

Is Phenol Red Broth Selective or differential?
Differential

MR (MR-VP) broth tests for?
Acids produced in glucose fermentation
Whether or not it uses glucose to produce an acid/acetoin

MR-VP broth Substrates?
Glucose

MR (MR-VP) broth product?
Acid

VP (MR-VP) broth product?
Acetoin

MR-VP broth positive result?
red

MR (MR-VP) broth reagents?
Methyl red

VP (MR-VP) broth reagents?
Barritt’s A&B

is MR-VP broth selective or differential?
Differential

VP (MR-VP) broth tests for?
Acetonin production from glucose

Sulfide Indole Motility product
Sulfide (H2S)

Sulfide Indole Motility positive result
Turbidity, motile

Sulfide Indole Motility selective or differential?
Differential

Sulfide Indole Motility tests for?
Tryptophan breakdown

Sulfide Indole Motility Substrate
Tryptophan

Sulfide Indole Motility Product
Indole

Sulfide Indole Motility positive result
red

Sulfide Indole Motility reagent
Kovac’s

Sulfide Indole Motility tests for?
Sulfide

Sulfide Indole Motility substrate?
Cystine

Sulfide Indole Motility Product?
Sulfide (H2S)

Sulfide Indole Motility positive result?
Black

O-F glucose tests for?
Oxidation or fermentation

O-F glucose substrate?
Glucose

O-F glucose product?
Acid

O-F glucose positive result?
Yellow

O-F glucose selective or differential?
differential

Triple Sugar Iron (TSI) tests for?
Sugar fermentation and Sulfide

Triple Sugar Iron (TSI) substrate?
Sugars and cystine

Triple Sugar Iron (TSI) product?
Acid and Sulfide (H2S)

Triple Sugar Iron (TSI) positive result when testing for sulfide?
Black

Triple Sugar Iron (TSI) positive result when testing for sugar fermentation?
Yellow
The butt and the top of the slant are analyzed, A standing for yellow and K standing for red
Ex. K/A = fermentation of glucose only, A/A = fermentation of glucose and 1 other sugar, K/K = no sugar fermentation

Triple Sugar Iron (TSI) selective or differential?
Differential

Simmon’s Citrate Agar tests for?
Citrate utilization

Simmon’s Citrate Agar substrate?
Citrate

Simmon’s Citrate Agar product?
Ammonia NH4

Simmon’s Citrate Agar positive result?
Blue

Simmon’s Citrate Agar selective or differential?
Differential

Blood Agar tests for?
Hemolysis (bursting of RBCs)

What does hemolysis look like in alpha cells?
Greenish colonies

What does hemolysis look like in beta cells?
Grey/white colonies, zone of clearing
What does hemolysis look like in gamma cells?
No hemolysis

Blood Agar substrate?
Blood cells

Blood Agar selective or differential?
selective

Starch Agar tests for?
Starch hydrolysis

Starch Agar substrate?
Starch
Starch Agar product?
Simple sugar

Starch Agar positive result?
Halo

Starch Agar reagent?
Iodine

Starch Agar differential or selective?
Differential

TSA Catalase tests for?
Catalase

TSA Catalase substrate?
Lactose

TSA Catalase reagent?
H2O2

TSA Catalase product?
Oxygen

TSA Catalase positive result?
Bubbles

TSA Catalase reagents?
H2O2

TSA Catalase selective or differential?
Differential

TSA Oxidase tests for?
Oxidase

TSA Oxidase substrate?
TMPD

TSA Oxidase product?
Reduced cytochrome C

TSA Oxidase positive result?
Purple

TSA Oxidase reagents?
TMPD

TSA Oxidase selective or differential?
Differential